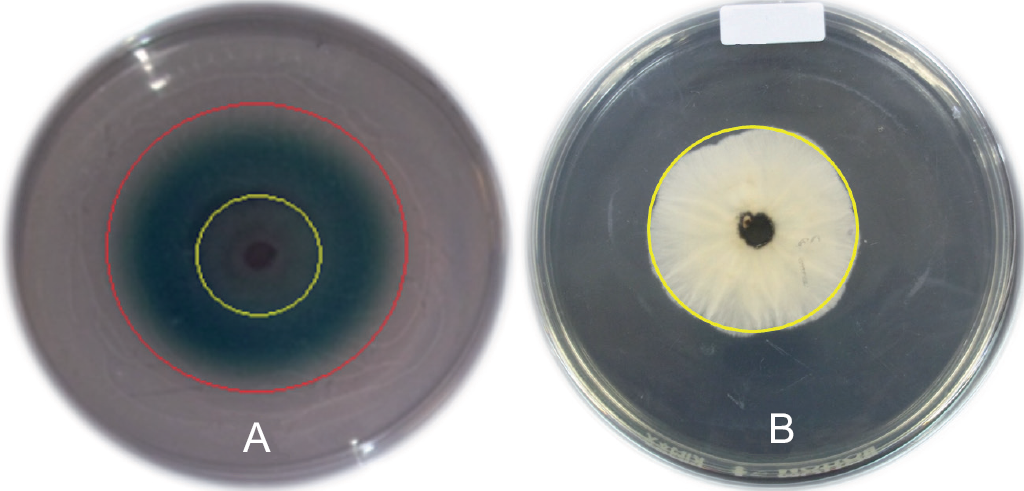

INTRODUCCIÓN
Los macromicetos lignícolas en su mayoría pertenecen al grupo de los basidiomicetos y son los organismos más eficientes en la degradación de la lignina, polímero natural de estructura compleja (Ruiz-Dueñas et al. 2014). Únicamente los hongos ligninolíticos y especialmente, los macromicetos lignícolas son capaces de mineralizar la lignina en conjunto con los otros componentes de la madera (Harris-Valle et al. 2014). En la degradación de estos compuestos están involucradas algunas enzimas fúngicas extracelulares tales como la lacasa (EC 1.10.3.2), manganeso peroxidasa (MnP, EC 1.11.1.14) y lignina peroxidasa (LiP, EC 1.11.1.13), las cuales poseen múltiples aplicaciones biotecnológicas en la industria papelera, textil, alimentaria, farmacéutica y ambiental (Osma et al. 2014).
Estudios recientes mencionan que la prospección enzimática en la micobiota nativa es una herramienta biotecnológica para enfrentar problemas ambientales como la contaminación del agua (Hernández-Luna et al. 2008, Tapia-Tussell et al. 2011 y Cruz-Ramírez et al. 2012). Se ha demostrado que la micobiota nativa posee la habilidad para decolorar agua contaminada con azul ácido 74, verde reactivo 19, rojo reactivo 195 (Tapia-Tussell et al. 2011), antraquinona, cristal violeta y colorantes tipo azo (Hernández-Luna et al. 2008). Además, se ha comprobado que las enzimas ligninolíticas poseen la habilidad para transformar o degradar plaguicidas de diferente grupo estructural tales como las triazinas (Chan-Cupul et al. 2014), organoclorados (Marco-Urrea y Reddy 2012), organofosforados (Huifang et al. 2013), entre otros. Por lo tanto, el número de investigaciones dirigidas hacia la búsqueda y estudio de nuevas especies y cepas de macrohongos lignícolas con alta capacidad para producir enzimas ligninolíticas se ha incrementado considerablemente en las últimas décadas (Fernández-Fernández et al. 2013).
En México, la diversidad fúngica se calcula entre las 140 000 y 200 000 especies, de las cuales menos del 10 % han sido estudiadas (Guzmán 1995). En cuanto a macromicetos se han descrito aproximadamente 4 000 especies (Guzmán 1998). Respecto a la magnitud de la riqueza de las especies fúngicas por entidad federativa aún se está lejos de contar con un conocimiento representativo. Sin embargo, el estado de Veracruz posee el mayor número de especies descritas, habiéndose registrado 1517 (Guzmán et al. 2003, Aguirre-Acosta et al. 2014). Pese a que México es uno de los países con mayor diversidad fúngica, se han realizados pocos estudios de prospección enzimática en macrohongos lignícolas para encontrar especies productoras de enzimas de importancia biotecnológica. Entre los estudios realizados destacan los trabajos de Hernández-Luna et al. (2008), Tapia-Tussell et al. (2011), Cruz-Ramírez et al. (2012) y Chan-Cupul (2014) desarrollados con especímenes colectados en los estados de Nuevo León, Yucatán, Hidalgo y Veracruz, respectivamente.
La prospección de la riqueza fúngica nativa en la búsqueda de cepas con potencial para la producción de enzimas de importancia biotecnológica, es una actividad prioritaria ante la constante pérdida de la biodiversidad de los ecosistemas locales. Por lo tanto, el presente estudio tuvo como objetivos aislar y seleccionar macromicetos nativos del estado de Veracruz con potencial para la producción de enzimas ligninolíticas. Asimismo, para las cepas con mayor potencial enzimático, se pretendió evaluar su actividad lacasa y manganeso peroxidasa (MnP) en tres medios de cultivo líquido y valorar así la producción de ambas enzimas bajo condiciones de fermentación sólida (paja de trigo, bagazo de caña y aserrín de pino).
MATERIALES Y MÉTODOS
Colecta, aislamiento e identificación de macromi-cetos lignícolas
Los carpóforos fueron colectados de diversos sitios en nueve municipios del estado de Veracruz, México en los meses de septiembre de 2011 a abril de 2012 (Cuadro I). El aislamiento del micelio se realizó a través de la desinfección de fragmentos (0.5-1.0 cm2) de los carpóforos con hipoclorito de sodio (5 %), alcohol etílico (70 %) y agua destilada. Los fragmentos desinfectados fueron depositados sobre placas con agar papa dextrosa (APD) suple-mentado con cloranfenicol (Lab. Sophia, México) y benomyl (Biesterfeld Co. USA) a una concentración de 3 ppm, para evitar el crecimiento de bacterias y hongos microscópicos (Chaparro et al. 2009). Las placas inoculadas se incubaron a 25 °C durante 8 días (d), el micelio emergente se transfirió a cajas de Petri con APD para la obtención de cultivos puros. Las cepas aisladas se conservaron a 4 °C en APD. La identificación de los carpóforos (Fig. 1) que dieron origen al micelio fueron identificados con base en sus características morfológicas por medio de claves taxonómicas especializadas (Gilbertson y Ryvarden 1987, Ryvarden 1991, Núñez y Ryvarden 2001, Guzmán 2008).

Cuadro I Municipios y localidades incluidos en la colecta de macromicetos lignícolas en el estado de Veracruz, México
Determinación cualitativa de la actividad enzimática ligninolítica
Para seleccionar las cepas enzimáticamente activas, se realizaron ensayos de coloración del ácido 2,2'-azi-no-bis[3-etilbenzotiazolin-6-sulfónico] (ABTS) en el medio de cultivo descrito por Rubilar-Araneda (2007), el cual contiene (g/L): glucosa (10), KH2PO4 (2), MgSO4●7H2O (0.5), CaCl2●2H2O (0.1), tartrato de amonio (0.2), ABTS (0.2) y agar (22) a un pH de 5.5.
El medio de cultivo se esterilizó en autoclave a 120 °C durante 15 min, el ABTS se añadió al enfriarse dicho medio de cultivo a 40-45 °C y se distribuyó en cajas de Petri de 90 mm de Ø. Posteriormente, se extrajo un disco de los hongos aislados en APD y se colocó en el centro de la caja Petri, las placas se incubaron 25 °C durante 8 d. La actividad enzimática (lacasa) se consideró positiva ante la presencia de un halo de oxidación de color verde-oscuro a verde-esmeralda (Rubilar-Araneda 2007). Cada 24 h se cuantificó el diámetro de la colonia del hongo y el diámetro del halo de oxidación del ABTS mediante una escuadra milimétrica. Con ambos valores, se calculó el índice de potencia (IP) dividiendo el diámetro del halo de oxidación entre el diámetro de crecimiento del micelio, para cada cepa se inocularon cuatro placas.
Actividad enzimática ligninolítica en fermentación líquida
Se seleccionaron tres cepas aisladas con el mayor IP para cuantificar la producción de lacasa y manganeso peroxidasa (MnP) en tres diferentes medios de cultivo líquido, los cuales fueron seleccionados por ser reportados en literatura científica como medios para la producción de enzimas ligninolíticas (Cuadro II). Los medios de cultivo se esterilizaron y se ajustaron a un pH de 4.5. Para la inoculación se depositaron cuatro discos de micelio agar (5 mm de 0) en un matraz Erlenmeyer de 250 mL de capacidad con 120 mL del medio de cultivo. Los matraces inoculados fueron incubados en agitación orbital a 120 rpm, 25 ± 1 °C y en ausencia de luz durante 12 d. Diariamente se extrajeron asépticamente alícuotas de 3 mL del extracto de cultivo para la cuantificación de la actividad de las enzimas lacasa y MnP, además del contenido de proteína. Previo a la cuantificación enzimática, el extracto de cultivo fue centrifugado a 7500 rpm durante 10 min para liberar el sobrenadante de los restos celulares. Para cada cepa se emplearon tres réplicas por medio de cultivo.
Actividad enzimática ligninolítica en fermentación sólida
Para conocer el potencial de las tres cepas con mayor IP para la producción de enzimas en sustratos orgánicos de bajo costo respecto a los cultivos en medios líquidos, se evaluó la producción de lacasa y MnP en tres sustratos agroindustriales disponibles para el estado de Veracruz, los cuales fueron: paja de trigo, bagazo de caña y aserrín de pino. Para ello, se preparó el inóculo que consistió en la reproducción masiva del micelio en semillas de sorgo (Sorghum vulgare Pers.). Las semillas se tamizaron para eliminar residuos y se hidrataron en agua por 24 h hasta obtener aproximadamente un 75 % de humedad. En bolsas de polipapel se depositaron 120 g de semillas de sorgo hidratadas y se esterilizaron a 125 °C por 15 min. Una vez que las semillas se enfriaron a temperatura ambiente, se abrieron las bolsas asépticamente y se les depositaron 10 discos de micelio agar (5 mm de Ø) de las cepas a estudiar. Las bolsas se incubaron a 25 ± 1 °C por 8 d. La bolsa con semillas de sorgo colonizadas se consideró como inóculo (Mata et al. 2011).
Para el crecimiento de los hongos en los residuos agroindustriales se homogeneizó cada sustrato a un tamaño de partícula de 0.5 cm a través del trozado y tamizado. Se pesaron cinco g de cada residuo agro-industrial, llevándolos al 100 % de su capacidad de retención de humedad y se depositaron en matraces Erlenmeyer de 250 mL de capacidad. Los matraces se esterilizaron a 125 °C durante 20 min, posteriormente se les adicionó el inóculo preparado previamente al 5 % (0.5 g). Los matraces inoculados fueron incubados estáticamente a 25 ± 1 °C en ausencia de luz durante 30 d. Se emplearon tres réplicas para cada residuo agroindustrial por cepa evaluada. Cada 72 h se colectó asépticamente 0.5 g de residuo agroindustrial para la cuantificación de la actividad lacasa, MnP y contenido de proteína. Para ello, se realizó un extracto enzimático que consistió en depositar 0.5 g de residuo agroindustrial colonizado en un tubo falcón con 5 mL de amortiguador acetato de sodio pH 4.5. Los tubos se agitaron horizontalmente durante 20 min, posteriormente, fueron centrifugados a 5000 rpm durante 10 min para sedimentar las partículas sólidas. El sobrenadante se empleó para la cuantificación enzimática.
Evaluación de la actividad enzimática
Las actividades lacasa, MnP y contenido de proteína se cuantificaron espectrofotométricamente. Para la actividad lacasa fue por la oxidación del ABTS (Sunil et al. 2011) a temperatura ambiente (27-25 °C) en una reacción que contiene 5.0 mM deABTS (100 μL), 100 mM de amortiguador acetato de sodio (800 μL, pH 4.5) y extracto enzimático (100 μL); el cambio en la absorbancia se midió durante 5 min a 420 nm (ε = 36000 mM/cm). Una unidad de actividad lacasa (U) se definió como la cantidad de enzima requerida para oxidar 1 μmol de ABTS/mL/min y se expresó como actividad específica (U/mg de proteína o U/mg de peso seco) y volumétrica (U/L) tanto en la fermentación líquida como en la sólida.
La actividad MnP se determinó por el método de Glenn y Gold (1983). La mezcla de reacción contenía lactato de sodio 25 mM (50 μL), MnSO4 2 mM (50 uL), albúmina de huevo al 0.1 % (50 μL), rojo fenol al 2 % (50 μL), amorgituador succinato-lactato (pH 4.5) 20 mM (50 μL) y extracto enzimático (700 μL). La reacción se inició al adicionar 50 μL de H2O2 (2 mM) y se detuvo a los cinco min con 50 uL de NaOH (2 N). La absorbancia fue leída contra un testigo sin MnSO4 en la reacción. El coeficiente de extinción molar del rojo fenol bajo las condiciones de reacción fue de 4460 mM/cm. Una actividad MnP (U) se definió como la cantidad de enzima requerida para transformar 1 umol de rojo fenol/mL/min y se expresó como actividad específica (U/mg de proteína o U/mg de peso seco) y volumétrica (U/L) tanto en la fermentación líquida como en la sólida.
El contenido de proteína total en fermentación líquida se cuantificó a través del método de Bradford en el que se emplea una curva patrón con valores conocidos (0, 0.0062, 0.0125, 0.025, 0.05, 0.1 y 0.2 mg/ mL) y albúmina de suero bovino como estándar. La curva patrón fue de Y = 0.1615 C - 0.0125 (Y = ab-sorbancia, C = concentración de proteína en mg/mL, R2 = 0.998).
Análisis de datos
Una vez probados los supuestos de normalidad y homocedasticidad, se realizaron análisis de varianza de una ruta y la comparación de medias para determinar los valores significativamente diferentes entre los valores máximos de la actividad lacasa y MnP por cada cepa, medio de cultivo y residuo agroindustrial empleado con el paquete Statgraphics Plus 5.1.
RESULTADOS
Colecta, aislamiento y actividad enzimática cualitativa
A partir de 105 ejemplares colectados, se obtuvieron 70 aislamientos (datos no mostrados) de macromicetos lignícolas nativos del estado de Veracruz, 41 de ellos presentaron actividad lacasa (Fig. 2). Las cepas fueron ubicadas en los géneros Pleurotus, Pycnoporus, Trametes, Stereum, Trichap-tum, Ganoderma, Schizophyllum, Lenzites, Xilaria, Daedalea, Cymatoderma, Dictyopanus, Polyporus, Lentinellus, Hexagonia, Phellinus y Pogonomyces. El hongo Cymatoderma elegans SBN4 presentó el mayor IP con un valor de 33.4, seguido por Pleurotus sp. SBN8, Pycnoporus sanguineus ACT1, Pleuro-tus djamor COA1, P. sanguineus SBN3, Trametes maxima SM9 y Trametes sp. SBN2, con 19.6, 16.0, 15.2, 13.8, 13.0 y 12.9, respectivamente (Fig. 3). Sin embargo, a pesar de que C. elegans SBN4 presentó el IP más alto, no fue seleccionado para los estudios subsecuentes debido a que produjo una escasa actividad lacasa en la evaluación cuantitativa (datos no mostrados). Por lo tanto, únicamente fueron seleccionados los aislamientos Pycnoporus sanguineus ACT1 (IP = 16.0), Trametes maxima SM9 (IP = 13.0) y Daedalea elegans PM7 (IP = 4.9), los cuales presentaron una suficiente y confiable actividad lacasa en una prueba cuantitativa. La determinación del IP empleando el halo de coloración del ABTS y el diámetro de la colonia resultó una herramienta fácil, rápida y económica para seleccionar los aislamientos que poseen la actividad lacasa. El valor del IP es un resultado arbitrario y no determina el potencial de un aislamiento para la producción de lacasa en fermentación sólida o líquida.
Fig. 2 Valoración cualitativa de la actividad lacasa. A) Cepa con actividad lacasa y B) Cepa sin actividad lacasa. El círculo rojo corresponde al halo de oxidación del ABTS y el círculo amarillo corresponde al crecimiento diametral del micelio del hongo
Actividad enzimática ligninolítica en fermentación líquida
En este ensayo la cepa T. maxima SM9 mostró la mayor actividad lacasa a los 7 d en el medio de cultivo Sivakumar con 9121.8 U/mg de proteína (32867.9 U/L, Fig. 4E). Este valor fue significativamente mayor (F = 25.3, P = 0.001) a las máximas actividades encontradas en el mismo medio de cultivo con D. ele-gans PM7 (Fig. 4A) y P. sanguineus ACT1 (Fig. 4C), al presentar una actividad lacasa de 1784.2 U/mg proteína (4349.4 U/L, a los 7 d) y 5422.2 U/mg proteína (16 256.5 U/L, a los 8 d), respectivamente.

Fig. 4 Actividad lacasa y manganeso peroxidasa (MnP) de Daedalea elegans PM7 (A y B), Pycnoporus sanguineus ACT1 (C y D) y Trametes maxima SM9 (E y F) en tres medios de cultivo en fermentación líquida: Bose (□), Koroljova (▼) y Sivakumar (▲). Media ± error estándar (n = 3).
En cuanto a la actividad MnP ocurrió algo similar a la actividad lacasa. En el medio de cultivo Sivaku-mar con la cepa T. maxima SM9 se obtuvo la mayor actividad de la enzima con 477.9 U/mg de proteína (1700.8 U/L) a los 7 d de cultivo (Fig. 4F). Este valor fue significativamente mayor (F = 37.2, P = 0.0004) a las máximas actividades obtenidas en el mismo medio de cultivo con D. elegans PM7 (Fig. 4B) y P. sanguineus ACT1 (Fig. 4D), al mostrar una actividad MnP de 40.0 U/mg de proteína (83.8 U/L, a los 8 d) y 41.0 U/mg de proteína (146.0 U/L, a los 5 d), respectivamente.
En los medios de cultivo Bose y Koroljova se detectaron bajas actividades lacasa y MnP para los tres aislamientos evaluados. En el medio de cultivo Bose la mayor actividad lacasa fue de 6.7 (22.0 U/L, a los 8 d), 3.1 (7.9 U/L, a los 3 d) y 12.9 (28.6 U/L, a los 12 d) U/mg de proteína para D. elegans PM7, P. sanguineus ACT1 y T. maxima SM9, respectivamente (Fig. 4A, C y E). Mientras que para la actividad MnP, la mayor fue de 5.5 (16.2 U/L, a los 6 d), 2.7 (7.0 U/L, a los 3 d) y 1.3 (3.3 U/L, a los 8 d) U/mg de proteína para D. elegans PM7, P. sanguineus ACT1 y T. maxima SM9, respectivamente (Fig. 4B, D y F). En cuanto a la actividad lacasa en el medio de cultivo Koroljova, las máximas fueron de 13.6 (29.4 U/L, a los 10 d), 673.0 (1379.9 U/L, a los 4 d) y 604.5 (1899.7 U/L, a los 9 d) U/mg de proteína en D. ele-gans PM7, P. sanguineus ACT1 y T. maxima SM9, respectivamente (Fig. 4A, C y E). Por su parte, las máximas actividades de la MnP en el medio Korol-jova para D. elegans PM7, P. sanguineus ACT1 y T. maxima SM9 fueron de 1.8 (3.6 U/L, a los 4 d), 22.8 (43.7 U/L, a los 4 d) y 37.6 (73.0 U/L, a los 6 d) U/ mg de proteína, respectivamente (Fig. 4B, D y F).
Actividad enzimática ligninolítica en fermentación sólida
Se evaluó la actividad lacasa y MnP de los aislamientos D. elegans PM7, P. sanguineus ACT1 y T. maxima SM9 sobre paja de trigo, bagazo de caña y aserrín de pino. En este ensayo la máxima actividad lacasa se obtuvo con el hongo P. sanguineus ACT1 cultivado sobre paja de trigo (a los 15 d) y sobre bagazo de caña (a los 6 d) con 1409.0 U/mg de peso seco (118.2 U/L) y 1404.8 U/mg de peso seco (76.7 U/L), respectivamente (Fig. 5C). Ambos valores fueron estadísticamente mayores (F = 12.9, P = 0.002) a la máxima actividad lacasa de D. elegans PM7 (a los 21 d) obtenida sobre paja de trigo con 133.9 U/mg de peso seco (27.2 U/L; Fig. 5A). Sin embargo, la máxima actividad lacasa de T. maxima SM9 obtenida en bagazo de caña (874.4 U/mg de peso seco = 62.1 U/L) a los 3 d de cultivo (Fig. 5E) fue estadísticamente igual (F = 2.54, P = 0.159) a las máximas actividades obtenidas por P. sanguineus ACT1 cultivado sobre paja de trigo (1409.0 U/mg de peso seco = 118.2 U/L) y bagazo de caña (1404.8 U/mg de peso seco=76.7 U/L; Fig. 5C). Aún sobre aserrín de pino, P sanguineus ACT1 (990.4 U/mg de peso seco = 100.1 U/L, a los 6 d, Fig. 5C) obtuvo significativamente (F = 32.9, P = 0.006) una mayor actividad lacasa en comparación con T. maxima SM9 (587.9 U/mg de peso seco = 60.2 U/L, a los 6 d, Fig. 5E) y D. elegans PM7 (11.8 U/mg de peso seco = 2.1 U/L, a los 9 d) establecidos sobre el mismo sustrato (Fig. 5A).

Fig. 5 Actividad lacasa y manganeso peroxidasa (MnP) de Daedalea elegans PM7 (A y B), Pycnoporus sanguineus ACT1 (C y D) y Trametes maxima SM9 (E y F) en fermentación sólida en tres residuos agroindustriales: paja de trigo (□), bagazo de caña (▼) y aserrín de pino (▲). Media ± error estándar (n = 3).
En cuanto a la actividad MnP, el bagazo de caña resultó mejor sustrato para la producción de la enzima para los hongos P. sanguineus ACT1 (a los 12 d) y T. maxima SM9 (a los 27 d) con 619.0 (33.8 U/l) y 519.6 (36.9 U/L) U/mg de peso seco (Fig. 5D y F), respectivamente. Ambos valores fueron significativamente mayores (F = 16.3, P = 0.003) a la máxima actividad MnP de D. elegans PM7 (Fig. 5B) producida en el mismo sustrato (65.6 U/mg de peso seco = 18.2 U/L) a los 12 d. En cuanto a la paja de trigo, resultó ser significativamente (F = 76.26, P = 0.0001) un mejor sustrato para la producción de MnP en P. sangui-neus ACT1 (397.0 U/mg de peso seco = 33.3 U/L, a los 12 d, Fig. 5D), aunque no con T. maxima SM9 (175.8 U/mg de peso seco = 30.6 U/L, a los 18 d, Fig. 5F) y D. elegans PM7 (115.4 U/mg de peso seco = 23.4 U/L, a los 6 d, Fig. 4B). Mientras que para el aserrín de pino, al comparar las máximas actividades, no se encontró diferencia significativa (F = 1.27, P = 0.34) para la producción de MnP en los tres hongos evaluados, las actividades MnP fueron de 243.5 (13.6 U/L), 317.4 (32.0 U/L) y 250.8 (25.6 U/L) U/mg de peso seco para D. elegans PM7 (a los 9 d, Fig. 5B), P. sanguineus ACT1 (a los 12 d, Fig. 5D) y T. maxima SM9 (a los 21 d, Fig. 5F), respectivamente.
DISCUSIÓN
En el presente estudio se cuantificó la actividad enzimática ligninolítica de macromicetos nativos del estado de Veracruz. Hasta la fecha son limitados los estudios enfocados en la búsqueda de especies fúngi-cas con alto potencial para la producción de enzimas ligninolíticas (Tapia-Tussell et al. 2011). Una herramienta fácil y económica para conocer la habilidad de una cepa para producir enzimas ligninolíticas como la lacasa, es la determinación cualitativa a través del halo de oxidación del ABTS (Rubilar-Araneda 2007, Sunil et al. 2011). Con este halo se calculó el índice de potencia (IP), definido como la relación del halo de oxidación y el crecimiento del micelio, este IP ha sido empleado en estudios similares (Márquez-Ortega 2004, Cruz-Ramírez et al. 2012, Antonio-Revuelta 2013). Sin embargo, el IP es un valor que sobreestima la actividad enzimática de una cepa, al no dar un valor preciso de su actividad. En este trabajo se observó que la cepa con mayor IP (Cymatoderma elegans SBN4) no fue precisamente la que produjo más actividad lacasa en fermentación líquida o sólida, de hecho no fue seleccionada para tales estudios al presentar la mínima actividad lacasa en el cultivo líquido. La oxidación del ABTS y la formación del halo de oxidación, puede haber sido ocasionada por otras peroxidasas fúngicas (aril-alcohol oxidasa, glucosa oxidasa) o por radicales libres (H2O2 u OH-).
La actividad lacasa y MnP en fermentación líquida se vio favorecida en el medio de cultivo Sivakumar en las tres especies evaluadas. El medio de cultivo Sivakumar posee la misma fuente y cantidad de carbono (glucosa) que el medio Bose. Sin embargo, posee menos cantidad de nitrógeno ((NH4)2SO4 y extracto de levadura), CaCl2, MgSO4 y KH2PO4. Es posible que la baja concentración de estos elementos en el medio de cultivo Sivakumar favoreciera la producción de ambas enzimas. Las enzimas lig-ninolíticas son producidas durante el metabolismo secundario bajo condiciones limitadas de nitrógeno (Kaal et al. 1995). Asimismo, en macromicetos lig-nícolas Jegatheesan et al. (2012) y Chan-Cupul et al. (2014) han reportado que concentraciones bajas de CaCl2 favorecen la actividad lacasa (0.1 mg/L) y MnP (0.01 mg/L), respectivamente. La función del CaCl2 en el medio de cultivo es mantener la estructura y estabilidad de ambas enzimas. Del mismo modo, Stoilova et al. (2010) sugieren que concentraciones bajas de MgSO4 contribuyen a mantener la estabilidad de la lacasa durante periodos prolongados de incubación. Sin embargo, las altas concentraciones de sales ((NH4)2SO4, CaCl2, MgSO4 y KH2PO4) en el medio de cultivo incrementan su potencial osmótico y en consecuencia, se puede reducir el crecimiento del micelio (Beever y Laracy 1986).
Aunado a lo anterior, el medio de cultivo Sivakumar, a diferencia del medio Bose, posee CuSO4 (0.001 g/L) y MnSO4 (0.002 g/L) en bajas concentraciones, ambos elementos son conocidos como inductores de lacasa (Fonseca et al. 2010) y MnP (Kamitsuji et al. 2005), respectivamente. El medio de cultivo Koroljova posee 50 % menos contenido de carbono (glucosa) en comparación con los medios Bose y Sivakumar. El contenido de carbono y el tipo de fuente son factores que influyen en la producción de enzimas ligninolíticas (Elisashvili et al. 2011). Por lo tanto, podría ser que el bajo contenido de carbono en el medio Koroljova sea la razón de haber encontrado menos actividad lacasa y MnP en comparación con el medio Sivakumar. Además, el medio Koroljova carece de CuSO4, compuesto inductor de lacasas (Shutova et al. 2008).
Los valores obtenidos indican que la cepa de T. maxima SM9 presenta una alta producción de lacasa, al menos en el medio de cultivo Sivakumar. La maxima actividad lacasa alcanzada por T. maxima SM9 se obtuvo a los 7 d de cultivo (9121.8 U/mg de proteína = 32867.9 U/L), valor mucho mayor que otras reportadas para la misma especie por Songulashvili et al. (2007) y Elisashvili et al. (2011) con 13 500.0 y 8600.0 U/L, respectivamente. Es bien conocido que el género Trametes es productor de lacasas, entre las especies reportadas están Trametes versicolor (1200 U/L, Rodríguez-Couto et al. 2002), Trametes ochracea (3900.0 U/L, Elisashvili et al. 2011) y Trametes trogii (14 200.0 U/L, Zouari et al. 2006). Sin embargo, los valores reportados son menores a los obtenidos con T. maxima SM9. Asimismo, T. maxima SM9 resultó excelente productor de MnP en el medio de cultivo Sivakumar con 477.9 U/mg proteína (=1700.8 U/L), valor superior al reportado para una cepa de T. maxima (610 U/L) por Elisashvili et al. (2011). Inclusive, otras especies de Trametes presentan menor actividad MnP, por ejemplo: Trametes zonata (360 U/L, Songulashvili et al. 2007), Trametes unicolor (590 U/L, Elisashvili et al. 2011) y Trametes versicolor (150 U/L, Lorenzo et al. 2002).
Adicionalmente, P. sanguineus ACT1 destacó por su buena producción de lacasa y MnP. Al igual que con T. maxima SM9, el medio de cultivo Sivakumar permitió la mayor producción de dicha enzima por P. sanguineus ACT1. Las máximas actividades para lacasa y MnP fueron de 5422.2 U/mg de proteína (16 256.5 U/L) y 41.5 U/mg de proteína (146.0 U/L), respectivamente. La actividad lacasa obtenida por P. sanguineus ACT1 es ligeramente menor a la actividad reportada por Ramírez-Cavazos et al. (2014) con una cepa nativa del noreste de México, la cual presentó 20 000 U/L en un medio enriquecido con jugo de tomate y glucosa/bactopeptona. La actividad MnP de P. sanguineus ha sido menos estudiada en comparación con la de la lacasa. Al respecto, Watanabe et al. (2012) reportaron una baja actividad de MnP (0.08 ABS/min) con una cepa de P. sanguineus cultivada en efluentes de la industria farmacéutica. Sin embargo, los valores reportados por Watanabe et al. (2012) no se pueden comparar con los de este estudio debido a que fueron presentados con una unidad de medición (ABS/min) diferente a la empleada en este trabajo (U/L y U/mg de proteína).
La actividad enzimática ligninolítica (lacasa y MnP) en macromicetos lignícolas depende de la composición del medio de cultivo empleado para su producción y es regulada por diversos nutrientes tales como la glucosa, nitrógeno y iones metálicos (Cu2+, Mn2+, Mg2+, Fe2+) (Elisashvili et al. 2011). Además, la producción de lacasa y MnP se ve afectada por numerosos factores involucrados en el cultivo tales como la composición y la fuente de nutrientes (C y N), el pH, la temperatura, la agitación y la presencia de inductores como etanol, alcohol veratrílico, compuestos análogos de la lignina, etcétera (Rodríguez-Couto et al. 2002).
La fermentación sólida para la producción de enzimas resulta más económica que la fermentación líquida en medios de cultivo con ausencia de inductores enzimáticos (Demir et al. 2011). Por lo tanto, si se desea producir enzimas con menor impacto ambiental y a menor costo, la fermentación sólida es una alternativa a considerar. Los resultados del presente estudio indican que la paja de trigo permitió la mayor actividad lacasa en D. elegans PM7 (133.8 U/mg de peso seco a los 21 d) y P. sanguineus ACT1 (1408.9 U/mg de proteína a los 15 d), mientras que en el bagazo de caña, T. maxima SM9 produjo su máxima actividad lacasa (874.4 U/mg de peso seco a los 3 d). En cuanto a la actividad MnP, las cepas P. sanguineus ACT1 (619.0 U/mg de peso seco a los 12 d) y T. maxima SM9 (519.5 U/mg de peso seco a los 27 d), presentaron la mayor actividad MnP sobre bagazo de caña. Para D. elegans PM7, en el aserrín de pino fue que se produjo la mayor actividad MnP (243.4 U/mg de peso seco a los 9 d). En fermentación sólida P. sanguineus ACT1 fue el hongo con mayor actividad lacasa y MnP, dejando en segundo término a T. maxima SM9 y D. elegans PM7. En la fermentación líquida fue T. maxima SM9 el hongo con mayor actividad lacasa, dejando en segundo término a P. sanguineus ACT1 y D. elegans PM7.
La composición química de los sustratos agroin-dustriales difiere entre sí. De acuerdo con el trabajo de López-Miranda et al. (2009) y Prinsen (2010), la paja de trigo (16.85 %) y el bagazo de caña (23.09 %) poseen menos lignina en comparación con el aserrín de pino (26.5 %), y puede ser que el menor contenido de lignina en la paja de trigo y el bagazo de caña facilite la accesibilidad a la celulosa, fuente de carbono para el crecimiento fúngico y síntesis enzimática. Esto da como resultado que la paja de trigo sea el mejor sustrato para la producción de lacasa, al menos en D. elegans PM7 y P. sanguineus ACT1. Por otra parte, el bagazo de caña resultó mejor sustrato para la producción de MnP, al menos en P. sanguineus ACT1 y en T. maxima SM9. Mientras que D. elegans PM7 prefirió el aserrín de pino. Sin embargo, no se debe descartar que la síntesis de enzimas ligninolíticas es una característica especies-cepa dependiente y que, además, la fuentes y composiciones nutrimentales tanto de cultivos líquidos y sustratos agroindustriales son un factor más a considerar en la producción de enzimas.
Este trabajo es una plataforma para continuar estudiando la micobiota nativa del estado de Veracruz, si se desea conservar el germoplasma fúngico a través de ceparios ante la constante pérdida de diversidad. Además de ser una antesala necesaria para los estudios sobre micorremediación en ambientes acuáticos y edáficos contaminados en el estado de Veracruz.
CONCLUSIONES
Por la amplia diversidad fúngica que prolife-ra en el estado en Veracruz es factible encontrar ejemplares de basidiomicetos lignícolas con potencial para la producción de enzimas ligninolíticas. Cuando se tiene un gran número de cepas fúngicas, la determinación del IP empleando la detección cualitativa de lacasas a través del halo de oxidación del ABTS, es una herramienta fácil, rápida y económica para seleccionar cepas productoras de lacasa. Sin embargo, es necesario realizar una evaluación cuantitativa en fermentación líquida para determinar si la cepa realmente produce la enzima. En fermentación líquida la cepa T. maxima SM9 destacó por su alta producción de lacasa y MnP. En el medio de cultivo Sivakumar las especies probadas tuvieron la mayor producción de lacasa y MnP. En fermentación sólida, P. sanguineus ACT1 destacó por su alta actividad lacasa tanto en paja de trigo como en bagazo de caña. Mientras que para la actividad MnP, las especies indicadas para producir la enzima son T. maxima SM9 y P. sanguineus ACT1 y el sustrato ideal para ello es el bagazo de caña.











 nueva página del texto (beta)
nueva página del texto (beta)





